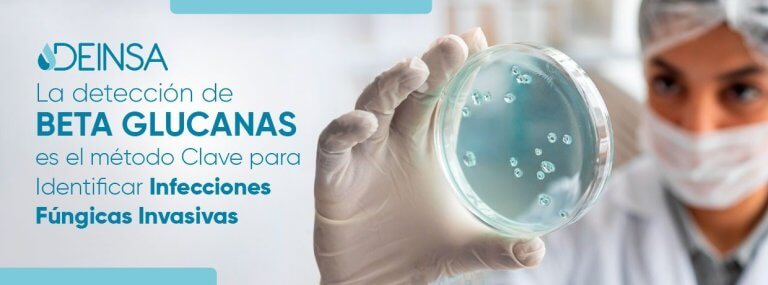

¿Cómo convertir a tus colaboradores en embajadores de marca?

¿Te has preguntado alguna vez qué haría que tus colaboradores hablen con orgullo de la empresa, compartan su experiencia y se conviertan en embajadores de marca por decisión propia? Ese día podrías estar viendo la diferencia entre una empresa que…